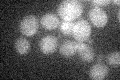
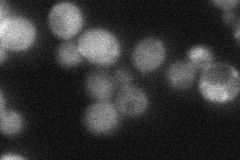
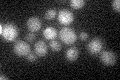

View description
Protein of unconfirmed function, involved in pyridoxine metabolism; expression is induced during stationary phase; forms a putative glutamine amidotransferase complex with Snz1p, with Sno1p serving as the glutaminase
Localization:
Intensity:
Fold change:
Significance:
-
C’ GFP library in SD
below threshold15.13 -
N' NOP1pr-GFP in SD

cytosol149.523 -
N' TEF2pr-mCherry in SD

cytosol97.3608 -
N' NATIVEpr-GFP in SD
cytosol23.56 -
N' TEF2pr-VC and Cyto-VN in SD

#N/A0 -
C’ GFP library in SD+DTT

cytosol17.871.18No -
C’ GFP library in SD+H2O2

cytosol14.980.98No -
C’ GFP library in Starvation Media
cytosol20.871.37No -
C’ GFP library on the background of Pup2-DaMP

below threshold -
C’ GFP library on the background of CCT mutant

below threshold15.25191.00746No
